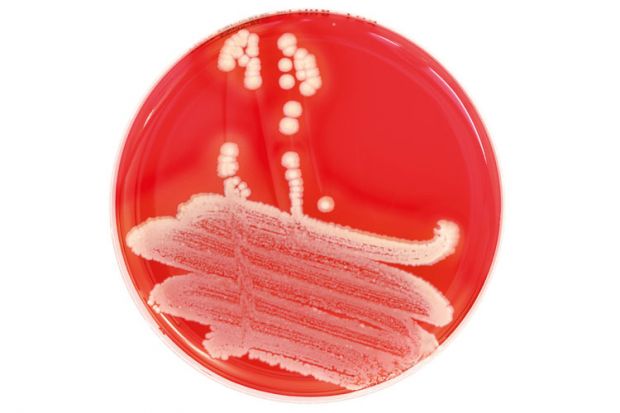

The Wellcome Trust is to fund more long-term research projects because of fears that the pressure to publish and the need to show research impact will prevent academics from successfully tackling the world’s most pressing challenges.
Over the next five years, the charitable foundation hopes to spend up to £5 billion, almost as much as it has spent over the previous decade, it announced in a new strategy this week.
Jeremy Farrar, the trust’s director, said that it planned to spend more on tackling the “really big challenges” – such as drug-resistant bacteria – in decade-long projects, as the organisation had done when it funded the sequencing of the human genome.
He argued that the “model of chasing the next paper in the next journal” could restrict the ability of scientists to solve large-scale problems.
“Some challenges…need to be solved in 10-year cycles,” he said.
The increased emphasis on long-term research was partly due to the increasing complexity of the world’s problems, Professor Farrar said, but was also a response to the growing short-term “pressure to publish” in journals.
Although not new, this pressure was on the rise, Professor Farrar said.
“The pressure to show impact in a short period of time…really worries me. I’m not sure there is sufficient space for people to dream,” he added.
He nevertheless stressed that traditional grants to fund researchers who have a “great idea” would remain “fundamental” to the trust’s work.
A £5 billion budget for the next five years would mark a significant increase in funding from the trust, which spent £6 billion over the past decade. Professor Farrar said that this boost in investment was made possible by “investments that are coming to fruition from the last five, 10 years” and would not eat into the trust’s £18 billion endowment.
“The investment team really have done a remarkable job,” he said. But he added a “crucial” caveat that the trust was “aiming” to spend £5 billion – it was not a certainty.
Wellcome’s new strategy comes in the run-up to November’s government spending review, when the research budget to 2020 will be announced. “There has been continued investment over the [past] 20 years, and now in 2015 we are reaping the rewards of it,” Professor Farrar said of government funding.
“If you turn off the support for [science]…then of course you won’t see the impact immediately – but five, 10, 20 years from now, you will see a fall-off”, a lag that created a political danger of underinvestment, he said.
But Professor Farrar stopped short of warning that the trust’s £5 billion could be held back if there were insufficient support from the government. There was no “equation” whereby Wellcome support would decline in line with state support, he said.
Another priority in the trust’s new strategy is to improve the diversity of the people it funds. Asked whether it might introduce demographic quotas on grant recipients, Professor Farrar said: “Whether quotas work or not is something we need to explore.”
POSTSCRIPT:
Print headline: Wellcome to fund more long-term projects to offset ‘pressure to publish’
Register to continue
Why register?
- Registration is free and only takes a moment
- Once registered, you can read 3 articles a month
- Sign up for our newsletter
Subscribe
Or subscribe for unlimited access to:
- Unlimited access to news, views, insights & reviews
- Digital editions
- Digital access to THE’s university and college rankings analysis
Already registered or a current subscriber?